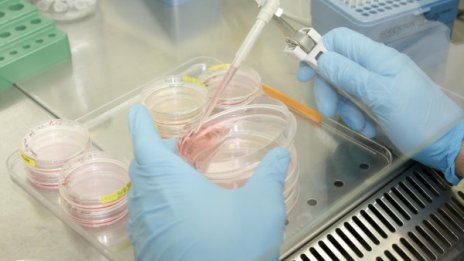

Новини
-
Като две капки вода - Кейт и Лила Мос поведоха звездния моден парад в Париж
-
Тенденции при чантите за лятото
-
Без крайности и глад: Фитнес режимът, който държи Емили Блънт във форма
-
Двата стълба на руската устойчивост, на които разчита Путин, се рушат
-
73 контрабандни бойни пистолета откриха митничари на "Капитан Андреево"
-
Германия спря първата си модерна програма за разрушители: Какво обърка проекта F126?
-
Гаджето на Коул Палмър удиви по бански
-
Две деца от школата на Славия са загинали на "Тракия", отивали на турнир
-
Промени: Трудовият стаж вече ще се изчислява по часове, а не по дни
-
Мондиал 2026: Англия се издъни срещу Гана
-
Две жени и мъж са намерени мъртви в общежитие в Угърчин
-
Бюджет 2026 година: По-скъпи винетки, вдигане на осигурителни прагове, инфлация 3,6%
-
Математикът, познал победителите на последните три мондиала, назова шампиона
-
Има уникална част от човешкото тяло, която еволюцията не може да обясни
-
Бюджет 2026 година: По-скъпи винетки, вдигане на осигурителни прагове, инфлация 3,6%
-
30% скок на винетките от 1 август: Годишната поскъпва от 49,60 евро на 64,50 евро
-
Празни хотели по морето: Високо ДДС, липса на работници, загубени пазари
-
Радев: Американските самолети ще напуснат летище "Васил Левски" до края на юни ВИДЕО
-
Украйна удари ключова нефтена база в Русия (ВИДЕО)
-
Радев: Войната в Украйна трябва да приключи, България ще подкрепи Киев
-
Най-мощното оръжие на Украйна са войниците, които отказват да се предадат

Nasdaq отчете четвърта поредна сесия на червено въпреки подкрепата от Micron
Nasdaq отчете четвърта поредна сесия на червено въпреки подкрепата от Micron  Мариана Трифонова: Европа преценява тона си с Китай
Мариана Трифонова: Европа преценява тона си с Китай  Ще изнасяме ли пшеница за Китай
Ще изнасяме ли пшеница за Китай  Проектът на Бюджет 2026 влиза за разглеждане в Министерския съвет на 1 юли
Проектът на Бюджет 2026 влиза за разглеждане в Министерския съвет на 1 юли  Кадър на деня за 25 юни
Кадър на деня за 25 юни  Берлин: Русия няма да спечели тази война
Берлин: Русия няма да спечели тази война 
 Луна в Стрелец: 3 зодии, за които всичко се нарежда на 26 юни 2026 г.
Луна в Стрелец: 3 зодии, за които всичко се нарежда на 26 юни 2026 г.  Зеленски одобри 40-дневна операция за оказване на натиск върху Русия
Зеленски одобри 40-дневна операция за оказване на натиск върху Русия  Бягство на хладно и уикенд туризъм: Накъде пътува Европа през лятото на 2026 г.
Бягство на хладно и уикенд туризъм: Накъде пътува Европа през лятото на 2026 г.  Късна емисия
Късна емисия  Каубойско шоу и забавни игри преди 250-годишнината на САЩ (СНИМКИ)
Каубойско шоу и забавни игри преди 250-годишнината на САЩ (СНИМКИ)  Париж забрани алкохола на обществени места заради горещата вълна
Париж забрани алкохола на обществени места заради горещата вълна 
 Спортът по телевизията днес, 26 юни
Спортът по телевизията днес, 26 юни  Мачовете по телевизията днес, 26 юни
Мачовете по телевизията днес, 26 юни  Еквадор обърна Германия и май излезе от групата
Еквадор обърна Германия и май излезе от групата  Кот д'Ивоар подчини и изхвърли симпатичния отбор на Кюрасао от Мондиал 2026
Кот д'Ивоар подчини и изхвърли симпатичния отбор на Кюрасао от Мондиал 2026  ПО МИНУТИ: Еквадор - Германия 2:1
ПО МИНУТИ: Еквадор - Германия 2:1  ПО МИНУТИ: Кюрасао - Кот д'Ивоар 0:2
ПО МИНУТИ: Кюрасао - Кот д'Ивоар 0:2 
 Дневен хороскоп за 26 юни, петък
Дневен хороскоп за 26 юни, петък  5 модела бански за всеки тип тяло
5 модела бански за всеки тип тяло  Сивата коса може да ви направи по-елегантни – ако знаете как
Сивата коса може да ви направи по-елегантни – ако знаете как  Марс преминава в Близнаци на 28 юни: Постигаме успехи, но внимаваме и за заблуди
Марс преминава в Близнаци на 28 юни: Постигаме успехи, но внимаваме и за заблуди  Таро карти за юли за всяка зодия
Таро карти за юли за всяка зодия  5 техники за самомасаж, които облекчават болката и отоците
5 техники за самомасаж, които облекчават болката и отоците 
 продава, Тристаен апартамент, 97 m2 Варна, Генералите, 290000 EUR
продава, Тристаен апартамент, 97 m2 Варна, Генералите, 290000 EUR  продава, Къща, 128 m2 Добрич област, гр.Балчик, 240000 EUR
продава, Къща, 128 m2 Добрич област, гр.Балчик, 240000 EUR  продава, Тристаен апартамент, 117 m2 София, Витоша, 305000 EUR
продава, Тристаен апартамент, 117 m2 София, Витоша, 305000 EUR  продава, Сутерен, Мазе, Партер, 63 m2 София, Витоша, 190000 EUR
продава, Сутерен, Мазе, Партер, 63 m2 София, Витоша, 190000 EUR  продава, Тристаен апартамент, 117 m2 София, Витоша, 305000 EUR
продава, Тристаен апартамент, 117 m2 София, Витоша, 305000 EUR  продава, Двустаен апартамент, 69 m2 София, Витоша, 190000 EUR
продава, Двустаен апартамент, 69 m2 София, Витоша, 190000 EUR 
 България между бума и капана на догонването – икономика на растящи цени, строителство и услуги
България между бума и капана на догонването – икономика на растящи цени, строителство и услуги  Най-богатите 10% от потребителите нанасят най-тежките щети на планетата - и вероятно сте сред тях
Най-богатите 10% от потребителите нанасят най-тежките щети на планетата - и вероятно сте сред тях  Морето в Гърция срещу родното море: Вечният спор къде е по-евтино
Морето в Гърция срещу родното море: Вечният спор къде е по-евтино  ЕЦБ: България вече е в еврозоната, докато останалите кандидати изостават
ЕЦБ: България вече е в еврозоната, докато останалите кандидати изостават  След началото на сезона: Прогнози за туризма по Черноморието
След началото на сезона: Прогнози за туризма по Черноморието  Европейците се страхуват да харчат пари и това вреди на икономиката
Европейците се страхуват да харчат пари и това вреди на икономиката 
 Светът е по-близо до ядрена катастрофа от всякога, предупреждава виден физик
Светът е по-близо до ядрена катастрофа от всякога, предупреждава виден физик  Представиха първия в света теснолинеен влак на водород
Представиха първия в света теснолинеен влак на водород  Астероид ще прелети край Земята този уикенд
Астероид ще прелети край Земята този уикенд  Кометата 3I/АTLAS може да е сред най-древните обекти, преминавали през Слънчевата система
Кометата 3I/АTLAS може да е сред най-древните обекти, преминавали през Слънчевата система  Марсоходът на НАСА откри вещество, което е в основата на живота на Земята
Марсоходът на НАСА откри вещество, което е в основата на живота на Земята  Откриха изгубен фрагмент от труд на Архимед: Може да възстанови древно знание
Откриха изгубен фрагмент от труд на Архимед: Може да възстанови древно знание